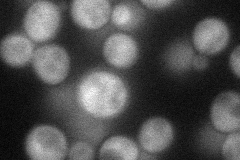
YHR129C
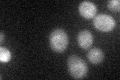
YHR129C

View description
Actin-related protein of the dynactin complex; required for spindle orientation and nuclear migration; putative ortholog of mammalian centractin
Localization:
Intensity:
Fold change:
Significance:
-
C’ GFP library in SD

cytosol19.89 -
N' NOP1pr-GFP in SD
cytosol52.9785 -
N' TEF2pr-mCherry in SD

punctate12.5709 -
N' NATIVEpr-GFP in SD

below threshold18.3419 -
N' TEF2pr-VC and Cyto-VN in SD

#N/A0 -
C’ GFP library in SD+DTT

cytosol18.890.94No -
C’ GFP library in SD+H2O2

cytosol25.181.26No -
C’ GFP library in Starvation Media
cytosol34.491.73No -
C’ GFP library on the background of Pup2-DaMP

vacuole membrane -
C’ GFP library on the background of CCT mutant

cytosol19.69420.98991No
